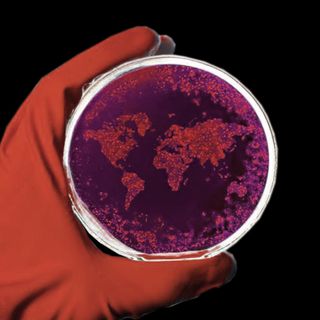

Sex Education Needs to Encompass Not Just Biology, But Sexuality, Mental Health, Too
In India, a niche group of sex educators are helping people set boundaries and understand sexuality and gender identity.

Sex education was that awkward class in high school for many of us, mostly received with awkward giggles, ‘let-this-class-be-done-with-already’ glances and a sense of discomfort experienced by teachers and students alike. Sex education in schools, if it’s present at all, suffers from the consequences of the taboo around the topic of sex in society. With teachers not equipped enough to teach sex ed and burdened with vast syllabi, sex education has largely been a topic that’s either quickly glossed over, with no room for any discussion, or just skipped entirely. This leaves much of sex education to organically happen within peer groups or through casual internet browsing.
Sex education classes were (and still are) rather selective in terms of the information they choose to convey. For example, ten years ago, my humble convent school skipped the topic of sex entirely and went right from explaining the menstrual cycle to explaining the period post-conception, with no information about what happens in the middle. It came as no surprise when many anecdotes about sex education classes from peers highlighted how sex education was largely a directive or a ‘speech’ about abstinence, seeking to induce fear of STI’s, laced with heteronormative, moral ideas regarding sexual intercourse within monogamous, heterosexual, marital relationships. They also largely put the responsibility to steer clear from unwanted pregnancies on the woman.
But, sex education is more than that — it not only encompasses the biology of sex, and STDs, but is also about providing a space for conversation about interpersonal relationships, learning how to set and express boundaries, and understanding gender and sexuality and its relation to mental health and well-being. With access to technology and larger school curricular reforms, educationists are beginning to envision learning outcomes beyond academic ones, thus equipping learners with critical thinking, the ability to communicate and develop social and emotional competencies that can be applied both within the schools and in society outside.
Related on The Swaddle:
Transgender Kids’ Brains Reflect Their Gender Identity in Structure and Function
Just like any subject, making sex education relatable requires educators to implement developmentally appropriate curricula, build on their learner’s prior knowledge, allow for engagement in the learning process, and create a safe space to facilitate and normalize conversations. Reshma Valliappan, founder of The Red Door Foundation, India — an organization that works with Municipal schools in Pune — believes that creating this safe space to discuss sex, sexuality and health in her classrooms comes with recognizing the stigma and discomfort, and even allowing students to shut their ears, and being open to letting students talk after class hours, as school classrooms can often lack a sense of anonymity. She also points out that understanding (cultural) context is key in student engagement, especially in her work in schools with high rates of violence, drug abuse and bullying.
For Valliappan, sex education is only a vantage point from which to create a space where students find a space to voice their understanding of their ever-changing world, learn how to be empathetic and respectful to people in general — not just to the ‘opposite sex.’ Humorously adding that she is often asked the question “Ladki ko kaise pataneka?” (How to woo a girl?) by her students, Valliappan asserts that the importance of consent, accepting rejection and establishing boundaries is what students need to see in the light of non-sexual/non- romantic relationships as well.
Even experimenting with different mediums can make an otherwise awkward subject easy to teach, and easy to consume or learn, such as art. “Art is a very comfortable space… (that) gets you to start thinking of things in a very real context” says Chaitanya Modak, a graphic novelist who facilitated a series of graphic novel workshops titled ‘Comics Epidemic’ for The Dharavi Biennale — organized by SNEHA, an organization that works on issues of maternal and child health in Mumbai — with a group of youth aged 14-24 in Dharavi. Not only did these workshops provide a communal space for sexual health information, they also helped the youth create complex narratives from their own lives using comics as a medium. Examples of the comics included a talk show on different views regarding masturbation, and a narrative of a young boy adjusting in a society that doesn’t consider him ‘macho enough.’ These conversations that were part of the workshop show how sex education is moving towards a ‘pleasure-driven’ discourse that is significant in addressing the silence around sex and sexuality.
Aakriti Pasricha, whose research on women’s experiences of pleasure sounds these beliefs when talking about how “good touch/bad touch” has conveniently kept aside any conversation about pleasure, and especially the pleasure of women. A focus on conversations around menstruation and pregnancy during sex education has also been coupled with little to no information about female reproductive anatomy (more than just the uterus). According to Pasricha, this has not only led to confused notions about the difference between the urethra and vagina, but given little space for women to understand their own bodies or even explore it. Moreover, these misconceptions show that the implementation of sex education curricula has been from an expert-driven (medical) perspective, which focuses only on biology, lacking any sort of experiential knowledge or female narrative. A pleasure-driven discourse in sex education is also crucial in breaking myths formed by Bollywood’s romanticized portrayal of sex that is devoid of consent-taking or any kind of negotiation during intercourse.
While conventional sex education focuses on one’s relationship with another human being, it’s interesting to see how a pleasure-driven discourse can help individuals explore and better understand themselves, as well as question and reflect on societal ideals that are otherwise left unquestioned in school.
Nihal Anabel, and his colleagues at the socio-emotional department of Muktangan Education Trust (Mumbai) — an organization that mentors seven municipal schools in Mumbai — help students see gender as a social construct and as being way beyond its binary understanding of male versus female. Queering sex education is a step toward a more inclusive sexuality education that recognizes the extent to which conventional sex-education has been propagating a heteronormative narrative, exclusive of LGBTQIA+ lives and experiences. The LGBTIA+ community has not only been victim to inaccessible health and sexual health care but also faces unique stressors on account of societal stigma. Creating a sex education discourse through a queer lens is crucial in fostering a society where all kinds of bodies and sexualities are made to feel safe and accepted, especially within a formative learning space such as the classroom. Anabel and his interns from TISS, Mumbai used the ‘GenderBread Person’ Model to discuss how gender identity, expression, attraction and biological sex all lie on a spectrum and aren’t necessarily connected to each other. While it was a challenge introducing these words to the students, it wasn’t something that students were completely unaware of. According to Anabel, this was more a reason to begin conversations on gender in younger grades so that more nuanced discussions on language and gender visibility can be made possible in higher grades.
Related on The Swaddle:
An Increasing Number of Women Are Buying Sex Toys, Thanks to the Internet
There still exist challenges in dealing with an overload of information, often misleading or false, on the internet, creating the need for an incremental curriculum, coming up with new pedagogical strategies and keeping in mind different learner level (yes, not every child grows or comprehends things at the same pace). However, these means of engagement show that we’ve come miles from sex education being an ‘abstinence-only’ discourse, and in incorporating a well-being perspective, beyond just an ‘illness’ lens. These discussions help further a human rights discourse to sex and sexuality education that imbibes the right to live with dignity for all, and a sense of equality, justice and a non-discriminatory attitude towards both, oneself as well as others.
Lorelle completed an M.A. in Social work in Mental health from TISS in 2017, and has been working in the education space ever since. Her research interests include mental health, culture and gender studies. When she finds time off from smashing the dominant discourse, she sings along to sad country songs and laughs at her own jokes.
Related


Shorter People May Be at a Greater Risk of Type 2 Diabetes